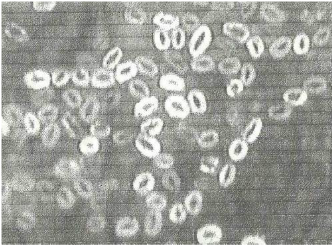

Porel纤维针织面料
特点: 春夏吸湿速干、秋冬吸湿发热、手感柔软、光泽柔和、永久的功能性.
为何需要Porel®纤维?
学生在室内学习、人们在早晚上下班或旅行者在户外歇息时,服装需要保暖;学生到室外进行体育运动,人们在户外运动或旅行者在野外旅行时,都会流汗,如果汗水不能迅速通过服装体系蒸发,人体将产生湿冷感,甚至于引起感冒生病。
Porel®纤维面料,特别适宜于学生群体、户外运动休闲群体或旅行者群体穿着使用,能使人体在较大身体运动状态发生变化且不更换衣着时,始终处于热湿平衡状态,保持贴身不湿、不冷、干爽、暖和、舒适。
什么是Porel®纤维?
| Porel纤维的改性从聚酯分子结构入手,在化学聚合大分子中导入亲水基团和柔性基团,制成改性聚酯切片,再纺成具有毛细管内腔的纤维,从而使纤维性能发生根本变化,使POREL纤维不会随着洗涤次数的增加导致吸湿速干、发热、保暖的功能下降,达到永久的功能性。 |  |
Porel纤维是一种抗起球中空纤维,纤维的中空管道可以使纤维集合体包含更多的静止空气,形成独特的保暖系统,该系统可以使织物显著增强隔热性能,从而使面料既保暖又轻薄,增加了人体的压感舒适性;纤维大分子中富有的柔性基团还可以降低纤维刚性模量,从而织物手感更加柔软,磨擦揉搓后不易起球。
Porel纤维集合体之间形成许多毛细管,和纤维的中空管道构成一个优良导湿系统,加上纤维大分子中引入亲水基团,又提高了纤维的导湿性。因此,人体穿着中空结构纤维面料时,始终处于热湿平衡状态,不论人体出汗或外界环境温度变冷时,中空结构纤维面料能使人体保持恒温、干爽、舒适状态。
Porel纤维大分子中引入柔性基团,手感柔软,同时纤维具有优良的抗起毛起球性能。 PorelTM纤维制作的服饰抗起毛起球、柔软、干爽、保暖,有效地把保暖、导湿相结合,这是Porel纤维对全天候服饰的贡献。
Porel纤维可以制作内衣、保暖内衣、T恤衫、运动服等,特别是棉盖PorelTM纤维纱线三层或两层针织服饰,是一种全天候服饰,不论穿着者是室内活动还是进行户外运动、旅行,都能够提供柔软、导湿、干燥、保暖服饰环境,使人体处于舒适状态。
Porel®纤维的优点

Porel®纤维制作的面料抗起毛起球、柔软、干爽、保暖。优越的湿气处理系统提供了穿着者在任何情况下同样有异常舒适的效果,优越的保暖系统使得服装面料轻薄、保暖。
Porel纤维-与皮肤相依的新型纤维材料!
舒适性纤维-穿着生理和心理要求
•夏天:吸湿速干
•冬天:吸湿发热
•春秋:保暖速干
•手感柔软,舒适性好,光泽柔和
Porel纤维-天然与高科技的结合
•非规则中空,柔软自卷曲,持久性强
•亲水性、舒适性好
大大提升调控湿热平衡的能力!
|
•纤维细化-柔软
|
 |
Porel®纤维超仿棉特性

Porel®纤维非常柔软

Porel纤维的模量小,易弯曲,柔软
Porel®纤维抗起球

通过控制生产工艺,适度降低共聚物的分子量,提高抗起球性能.
Porel®纤维保暖轻量化


Porel®纤维导湿性

毛细管空腔导湿系统,以及大分子中引入亲水基团毛细效应显著,水扩散在3秒一下
Porel®纤维快干性

1小时水分残留率小于30% (日本纺检: Porel23%)
Porel®纤维隔热性
毛细管和中空两组保暖系统,静止空气含量提高,隔热效果好
![]()
宁波广源纺织品有限公司位于北仑小港工业园区,杭州湾跨海大桥南段,紧靠北仑港,交通便利。是一家专业从事高品质、高附加值新型功能性针织面料研发、设计、生产、销售于一体的现代纺织企业,公司占地面积3万多平方,现有员工300余名.拥有香港立信ECO环保型常温、高温染整机,台湾力根、香港立信定型烘干机,意大利BINCO割幅机,奥林泰克斯测配色系统,英国WeriVide评审灯箱,万吨级污水处理站,日本福源、德国德乐、迈耶针织大圆机等织造、印染生产设备,年生产针织面料1万吨.公司是第一批国家级印染准入企业,已经通过全球生态纺织品标签OEKO-TEX100、有机棉OE100、ISO9001、ISO14001体系等多项认证。获得发明和实用新型专利十项,多款面料入围“中国流行面料”,与香港理工大学、东华大学、宁波纺织服装学院、青岛大学等国内外多所高校和科研机构有深入研发合作。获宁波市科技型企业,针织面料开发基地企业,称号被业内誉为“健康、时尚、科技、环保”面料引领者.
![]()
宁波广源纺织品有限公司

400电话:400-188-7001
电话:0574-55221907、55221902、55221908、55221906、55221911、55221919
传真:0574-55221900
邮箱:fhp9397@126.com; gyyx11@gy-nb.com; gyyx8@gy-nb.com
地址:浙江省宁波市北仑区戚家山街道沿江支路2号
| * 联系人: | 请填写您的真实姓名 |
| * 手机号码: | 请填写您的联系电话 |
| 电子邮件: | |
| * 采购意向描述: | |
| 请填写采购的产品数量和产品描述,方便我们进行统一备货。 | |
| *验证码: |
|
相关资讯
| 我要评论: | |
| *内 容: |
(内容最多500个汉字,1000个字符) |
| 验证码: | 看不清?! |


















共有-条评论【我要评论】